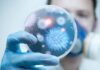
La física cuántica colabora en la lucha contra las infecciones y el cáncer

Ciudad de México., 19 Jul-22 (Agencia).- Una de las principales quejas de Prime Video es su interfaz que se quedó lejos de lo que ofrece Netflix, Disney+ y hasta el mismo HBO Max. Amazon al parecer escuchó los comentarios y ya desarrolló la nueva interfaz que estará llegando a la aplicación.
Amazon define su nueva interfaz como “menos ocupada y abrumadora para nuestros clientes”, al final las similitudes con Netflix serán inevitables por algunos elementos.
Iniciamos con una columna del lado izquierdo donde se mostrarán diferentes iconos con los elementos más importantes de la aplicación: búsqueda, inicio, tienda, TV en vivo, contenido gratis y mi contenido.
En la parte de inicio se mostrará el contenido más destacado de series, películas, programación de televisión. Al entrar en la tienda la zona izquierda veremos los diferentes canales que se pueden contratar dentro de la aplicación.
Un detalle notorio será que todo el contenido que se debe pagar contará con un icono de bolsa de compras en color dorado. Amazon mencionó que el rediseño de Prime Video ha sido un proyecto de 18 meses supervisado por Ben Smith, el responsable de liderar el cambio de Hulu en 2017.
La empresa espera que el nuevo diseño de iOS y en web se encuentre disponible en los próximos meses, mientras en Fire TV y Android TV estará llegando durante la semana, aunque no se aclaró si será en un inicio para Estados Unidos.
Un detalle curioso es que la app de PlayStation 3 y de Apple TV de tercera generación no recibirán la actualización, aunque aclaran que seguirán funcionando con la interfaz actual.
Por el momento no se ha revelado cuándo se actualizará la aplicación en otras regiones.